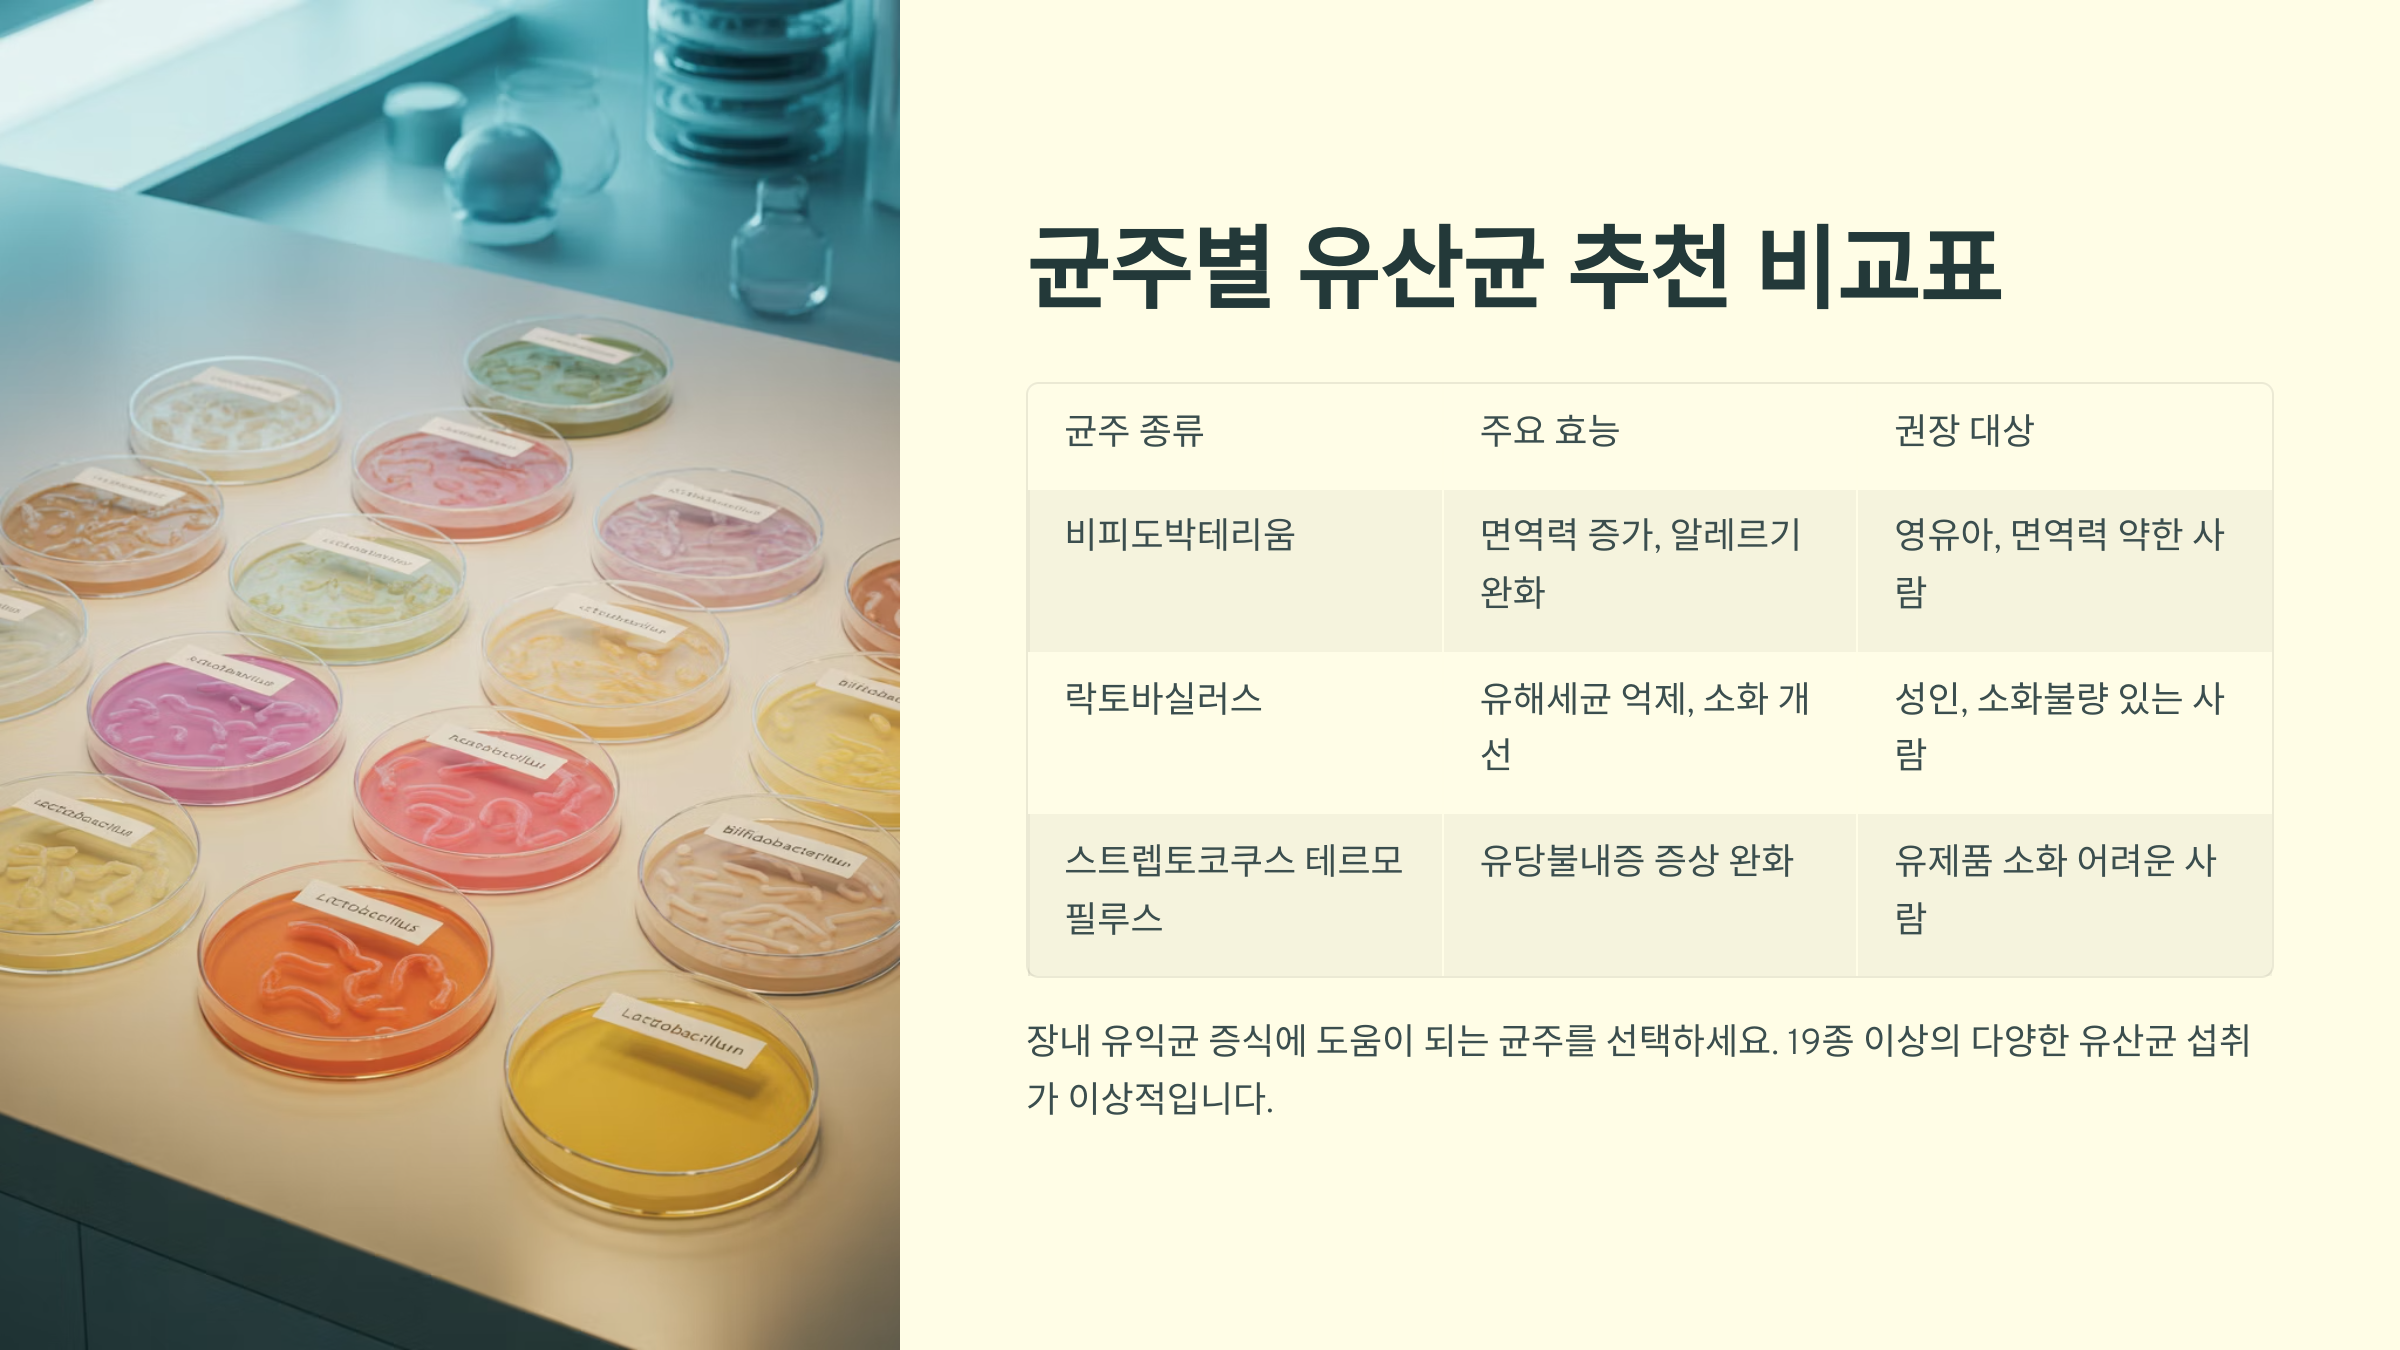

유산균은 요즘 건강기능식품 중에서도 가장 많이 찾는 영양제 중 하나예요. 장 건강, 면역력, 심지어 피부 상태까지 유산균이 관여한다고 하니, 이제는 선택이 아닌 필수죠. 👏
하지만 종류도 많고, 균주도 다 다르고, 먹는 시간도 제각각이니 헷갈릴 수밖에 없어요. 그래서 이번 글에서는 유산균이 무엇인지부터, 어떤 제품이 좋은지, 복용법과 주의사항까지 ‘2025년형 유산균 가이드’를 제대로 알려드릴게요! 🦠

유산균이란? 장 속 필수 균주 🧫

유산균은 말 그대로 ‘젖산을 만들어내는 균’이에요. 이 균들은 우리 몸, 특히 장 속에서 유익균으로 작용하면서 건강한 장내 환경을 만들어줘요. 우리 장에는 100조 마리 이상의 세균이 살고 있는데, 이 중 유익균과 유해균의 균형이 건강의 핵심이에요.
유산균은 장 속 환경을 산성으로 만들어 유해균의 번식을 억제하고, 소화 효소를 도와 음식의 흡수를 돕는 중요한 역할을 해요. 장내 환경이 깨지면 변비, 설사뿐 아니라 피부 트러블, 피로, 면역 저하까지 다양한 문제로 이어지죠.
대표적인 유산균 종류에는 락토바실러스, 비피도박테리움, 스트렙토코커스 등이 있어요. 이들은 각각 작용 부위나 기능이 다르기 때문에 목적에 맞게 선택하는 것이 중요하답니다.
내가 생각했을 때 유산균은 몸속 정원사를 고용하는 것과 같아요. 꾸준히 관리해주면 꽃(건강)이 피고, 방치하면 잡초(유해균)가 자라죠! 🌱
유산균의 건강 효과 총정리

유산균을 꾸준히 복용하면 장 건강뿐만 아니라 전신 건강에도 긍정적인 효과를 줄 수 있어요. 단순히 ‘화장실 잘 가게 해준다’ 이상의 역할을 한다는 거, 알고 있었나요?
1️⃣ 장 내 환경 개선 유산균은 유해균의 성장을 억제하고, 유익균의 비율을 높여줘요. 이로 인해 설사, 변비, 가스, 복부 팽만 등이 완화돼요.
2️⃣ 면역력 향상 장에는 면역세포의 70% 이상이 모여 있어요. 유산균은 면역세포의 활동을 조절하고 바이러스와 세균의 감염을 줄이는 데 도움을 줘요.
3️⃣ 피부 개선 장 건강과 피부는 연결돼 있어요. 장내 독소를 줄이면 아토피, 여드름, 지루성 피부염 등의 피부 트러블도 줄어든답니다.
4️⃣ 체중 관리 특정 유산균은 장내 대사 기능에 관여해 체지방 축적을 줄이고, 식욕을 조절하는 데 도움을 줄 수 있어요. 물론 식단과 병행해야 효과적이에요.
균주별 유산균 추천 비교표
유산균은 종류가 정말 많아요. 하지만 어떤 균주가 어떤 효과를 내는지 알면, 제품 선택이 훨씬 쉬워져요. 아래 표를 통해 주요 균주들을 정리해봤어요!
🧬 유산균 균주별 효과 비교
| 균주명 | 주요 효과 | 추천 대상 | 비고 |
|---|---|---|---|
| Lactobacillus rhamnosus GG | 면역 증진, 설사 예방 | 소아, 항생제 복용자 | 가장 많이 연구된 균주 중 하나 |
| Bifidobacterium lactis | 장내 유해균 억제 | 성인, 노인 | 노화에 따른 장 기능 저하에 도움 |
| Lactobacillus plantarum | 염증 완화, 피부 개선 | 피부 트러블 고민자 | 피부 마이크로바이옴 균형 회복 |
| Lactobacillus gasseri | 복부지방 감소 | 다이어트 중인 사람 | 체지방 감소 임상 결과 있음 |
이제 ‘많이 들어간 제품’보다 ‘내게 필요한 균주가 들어간 제품’을 고르는 게 더 중요하다는 거, 알겠죠? 👍
연령별·증상별 유산균 추천

연령이나 증상에 따라 필요한 유산균도 달라요. 아래 추천 리스트를 참고해서, 자신에게 꼭 맞는 제품을 찾아보세요!
👶 어린이: Lactobacillus rhamnosus GG + Bifidobacterium breve 장 면역 강화, 항생제 복용 후 회복에 좋아요.
👩 성인 여성: Lactobacillus reuteri + Lactobacillus crispatus 질 건강, 소화, 피부 개선에 도움돼요.
👨 성인 남성: Lactobacillus gasseri + Bifidobacterium lactis 복부지방 감소, 장 기능 개선, 대사 증후군 예방 효과가 있어요.
👵 중장년층: Bifidobacterium longum + Lactobacillus casei 변비 완화, 장내 염증 완화, 면역 강화에 좋아요.
복용 시기와 복용법 💊

유산균을 먹는 타이밍과 방법에 따라 효과가 크게 달라질 수 있어요. 아래 복용 팁을 잘 기억해두면 장 속 유산균이 살아남을 확률도 훨씬 높아져요!
📌 복용 타이밍 공복 또는 식사 30분 전이 가장 좋아요. 이때 위산이 덜 분비되기 때문에 유산균이 장까지 살아 도달할 확률이 높아요.
📌 함께 먹으면 좋은 성분 프리바이오틱스(식이섬유), 아연, 비타민C는 유산균의 활동을 도와줘요. 프리바이오틱스가 유산균의 먹이 역할을 하기 때문이죠.
📌 피해야 할 조합 항생제를 복용 중이라면 최소 2시간 이상 간격을 두고 유산균을 먹어야 해요. 항생제가 유산균도 죽일 수 있거든요.
📌 꾸준함이 핵심 유산균은 ‘복용을 멈추면 사라지는’ 영양제예요. 최소 3개월 이상 꾸준히 복용해야 장내 유익균 환경이 자리잡아요.
보관법과 주의사항 ⚠️

유산균은 살아있는 생균이기 때문에 보관이 매우 중요해요. 잘못 보관하면 효과가 거의 사라질 수도 있어요.
❄️ 냉장보관 필수? 요즘 제품은 기술이 좋아져서 실온 보관 가능한 제품도 많지만, 기본적으로 서늘하고 직사광선이 없는 곳에 보관하는 것이 좋아요. 개봉 후에는 냉장 보관이 안전해요.
💧 습기 주의 유산균은 습기에 약해요. 욕실이나 주방 근처는 피하고, 병을 열었다면 꼭 단단히 닫아주세요.
💊 과다 복용은 금물 유산균을 과하게 먹는다고 해서 좋은 게 아니에요. 오히려 복부 팽만, 가스가 생길 수 있어요. 하루 권장량을 지켜주세요.
👶 어린이 유산균 어린이는 반드시 '어린이 전용 제품'을 사용해야 해요. 성인용은 함량이 높아 장에 부담이 될 수 있어요.
FAQ

Q1. 유산균은 언제 먹는 게 가장 좋나요?
A1. 공복 또는 아침 식사 30분 전이 가장 흡수율이 높아요. 위산 분비가 낮을 때가 유산균 생존률이 높거든요.
Q2. 항생제랑 같이 먹어도 되나요?
A2. 가능하지만 최소 2시간 간격을 두고 복용해야 해요. 항생제가 유산균까지 죽일 수 있어요.
Q3. 유산균 먹으면 변이 더 자주 나오는데 괜찮나요?
A3. 네, 장 환경이 개선되는 과정에서 생기는 일시적인 현상일 수 있어요. 며칠 지나면 안정돼요.
Q4. 다이어트에도 유산균이 도움이 되나요?
A4. 네, 특정 균주는 지방 축적을 줄이고 대사 기능을 활성화해줘요. 식단과 병행하면 더 효과적이에요.
Q5. 변비가 심한데 어떤 유산균이 좋을까요?
A5. Bifidobacterium lactis, Lactobacillus casei가 변비 개선에 특히 효과적이에요.
Q6. 공복에 먹으면 속 안 쓰릴까요?
A6. 대부분 문제 없지만, 속이 예민한 분은 식후 복용해도 괜찮아요. 꾸준함이 더 중요해요.
Q7. 식물성 유산균은 뭔가요?
A7. 발효채소 등에서 유래한 유산균으로, 위산 저항성이 높고 장에 도달하는 생존력이 강한 편이에요.
Q8. 유산균을 계속 먹어야 하나요?
A8. 유산균은 몸속에서 정착하지 않기 때문에, 꾸준히 먹는 것이 좋아요. 멈추면 효과도 줄어요.